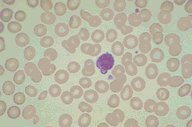

Description
This slide shows a high dry view of a Wright's stained blood smear
of a patient with heterozygous beta thalassemia. Some variation in
size and shape is apparent as is modest microcytosis and
hypochromia. Platelets are also seen.
|
|
Click on this image
to enlarge it, then
on Back buttom
in the Netscape Menu
to shrink it back down



|